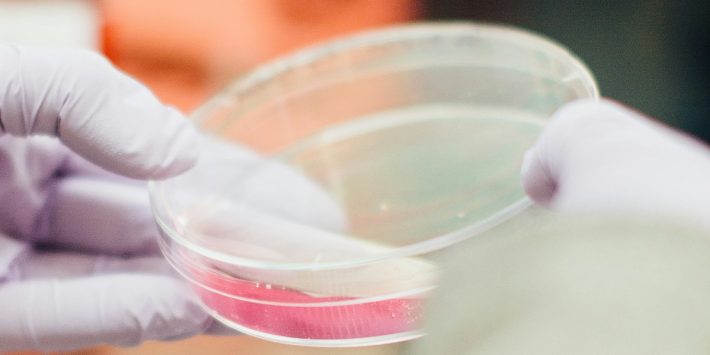

六部门联合实施完善数据流通安全治理促进要素市场化方案
《方案》从明晰企业数据流通安全规则、加强公共数据流通安全管理、强化个人数据流通保障、完善数据流通安全责任界定机制、加强数据流通安全技术应用等七个方面作出具体部署。…
《方案》从明晰企业数据流通安全规则、加强公共数据流通安全管理、强化个人数据流通保障、完善数据流通安全责任界定机制、加强数据流通安全技术应用等七个方面作出具体部署。…
数据标注是对数据进行筛选、清洗、分类、注释、标记和质量检验等加工处理,培育壮大数据标注产业对于提升数据供给质量,推动人工智能创新发展具有重要支撑作用。…
在《指引(试行)》中强调了加快构建政务数据共享交换平台、深化公共资源交易平台整合共享、推进技术交易市场建设和完善数据资源登记规则的重要性。…
标签:数据共享数据基础制度数据基础设施数据安全数据市场数据流通
《指引》阐述了国家数据基础设施概念内涵、发展愿景、总体功能、总体架构,从数据流通利用、算力底座、网络支撑、安全防护等四个方面指明具体建设方向。…
为了便利个人信息出境活动,规范个人信息出境个人信息保护认证工作,保护个人信息权益,促进个人信息高效便利安全跨境流动,根据相关法律法规制定本办法。…
《意见》完整准确全面贯彻新发展理念,统筹发展和安全,面向数据采集汇聚、计算存储、流通交易、开发利用、安全治理和数据基础设施建设,从八个方面部署了系列政策举措。…
以中医医院高质量发展为导向,以患者为中心,以业务应用为核心,以数据资源为关键要素,充分运用新一代信息技术,统筹发展和安全,推动医院业务与信息技术深度融合。…
制定发布包括基本准则在内的国家统一的可持续披露准则,是促进企业践行可持续发展理念、更好地参与全球经贸投资活动、提高国际竞争力、推动高质量发展的有效途径。…
推动钢材脱碳成为恒隆实现范围3温室气体减排目标的关键。此次恒隆与宝钢的低碳排放钢材交易,彰显了房地产行业领导者助力中国力争实现2060年前碳中和目标的又一案例。…
年会主题为“ESG理念20年:可持续金融的回顾与展望”,旨在回顾ESG理念诞生、发展和演进过程,并结合中国绿色金融和ESG发展现状,深入探讨当前ESG热点问题,展望可持续金融的机遇和挑战。…